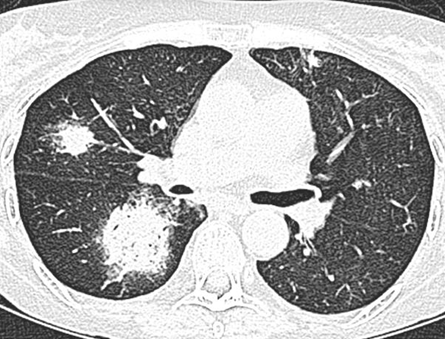

La nuova era dell’Alzheimer: una sfida per il neuroradiologo
Monitoraggio delle terapie anti-amiloide e gestione delle ARIA
L’approvazione di anticorpi monoclonali anti-amiloide, come lecanemab e donanemab, sta trasformando il ruolo del neuroimaging nella gestione della malattia di Alzheimer (AD). Sebbene l’effetto sulla progressione clinica consista principalmente nel rallentamento del declino, queste terapie rendono il radiologo un attore attivo e decisionale nel percorso di cura.
Il ruolo chiave dell’imaging: oltre la diagnosi
La RM e la PET amiloide sono diventate strumenti dinamici per guidare la terapia e monitorarne la sicurezza:
- Diagnosi ed eleggibilità: la RM esclude altre cause di declino cognitivo e identifica fragilità vascolari preesistenti.
- Monitoraggio biologico: la PET conferma la presenza di patologia amiloide e documenta l’efficacia della clearance post-trattamento.
- Gestione delle complicanze: la RM è mandatoria per rilevare le ARIA (amyloid-related imaging abnormalities), distinguibili in edema (ARIA-E) e microemorragie (ARIA-H).
Risultati e sfide: il carico di lavoro
L’integrazione di questi protocolli richiede una riorganizzazione dei dipartimenti:
- Frequenza: sono raccomandate circa 3–4 RM di monitoraggio nel primo anno.
- Efficienza: i referti sono spesso necessari entro 24 ore dall’acquisizione per convalidare l’infusione successiva.
- Urgenze: il radiologo deve distinguere prontamente tra ARIA e ictus ischemico (“stroke mimic”) per evitare trattamenti trombolitici incongrui.
Messaggio chiave
L’era delle terapie anti-amiloide richiede la standardizzazione dei protocolli e una formazione specifica sulle ARIA. Il successo di questo cambiamento di paradigma dipenderà dalla stretta collaborazione multidisciplinare tra neuroradiologi, neurologi e medici nucleari.
Per approfondire
Anzalone N., De Rimini M. L., Gandolfo N. The new era of Alzheimer’s disease: a possible burden for radiologists? La Radiologia Medica (2026).
https://doi.org/10.1007/s11547-026-02194-0
Diagnostica delle masse renali: il valore dello score ccLS
Accuratezza della mpMRI nella caratterizzazione del carcinoma a cellule chiare
La gestione delle piccole masse renali (SRM) è complessa a causa della loro eterogeneità istologica. Il Clear Cell Likelihood Score (ccLS) è un sistema di reporting per la RM multiparametrica (mpMRI) progettato per stimare in modo standardizzato la probabilità di carcinoma renale a cellule chiare (ccRCC).
Lo studio: validazione rispetto alla biopsia
Uno studio ha confrontato le prestazioni del ccLS con i risultati della biopsia percutanea, analizzando la correlazione tra lo score radiologico e l’istologia definitiva.
- Metodologia: il sistema assegna un punteggio da 1 a 5 basandosi su criteri di segnale T2, presenza di lipidi intracellulari (sequenze in/out-of-phase) e pattern di enhancement dinamico.
- Soglia diagnostica: un cutoff ccLS ≥ 4 è stato identificato come parametro ottimale per la diagnosi di ccRCC.
I risultati: un’alternativa valida alla biopsia?
L’analisi dimostra l’efficacia del sistema nella pratica clinica:
- Accuratezza: utilizzando il cutoff ≥ 4, il ccLS ha mostrato una sensibilità del 79% e una specificità dell’85%.
- Valore predittivo: i punteggi ccLS 4 e 5 hanno mostrato un’alta probabilità istologica di ccRCC (fino al 90%).
- Gestione clinica: lo score consente di stratificare i pazienti, suggerendo la sorveglianza attiva per i punteggi bassi e riducendo il ricorso a procedure invasive non necessarie.
Messaggio chiave
Il ccLS si conferma uno strumento robusto per la gestione non invasiva delle SRM. La sua applicazione sistematica può ottimizzare il processo decisionale clinico, riducendo il rischio di sovratrattamento delle lesioni benigne.
Per approfondire
Brembilla G., Pennella R., Siciliano G., et al. Diagnostic performance of the clear cell likelihood score (ccLS) for small renal masses characterization in patients undergoing percutaneous biopsy. La Radiologia Medica (2026).
https://doi.org/10.1007/s11547-025-02169-7
Dual-energy CT nell’ictus: emorragia o mezzo di contrasto?
Performance diagnostica e gestione della dose radiante
Dopo le procedure di trombectomia meccanica, la distinzione tra emorragia intracerebrale (ICH) e stravaso di mezzo di contrasto (CS) rappresenta una sfida critica. La dual-energy CT (DECT) emerge come la soluzione tecnologica di elezione per questa diagnosi differenziale vitale.
Il contesto: la necessità di precisione
La gestione clinica immediata dipende dalla natura dell’iperdensità rilevata alla TC post-procedura: un’emorragia richiede protocolli terapeutici opposti (es. inversione dell’anticoagulazione) rispetto a un semplice stravaso iodato. Una metanalisi sistematica ha valutato l’accuratezza della DECT e l’impatto sulla dose radiante.
I risultati: eccellenza diagnostica e sicurezza
Lo studio conferma l’affidabilità superiore della DECT:
- Accuratezza: la sensibilità e la specificità combinate sono risultate rispettivamente del 93% e del 95% nella distinzione tra sangue e iodio.
- Mappe virtuali: l’utilizzo delle mappe Virtual Non-Contrast (VNC) consente di isolare il segnale ematico “sottraendo” matematicamente lo iodio dall’immagine.
- Dose radiante: l’analisi ha dimostrato che la DECT non comporta un incremento significativo della dose rispetto alla TC convenzionale (single-energy).
Messaggio chiave
La DECT rappresenta lo standard di riferimento nel post-trattamento endovascolare. La sua capacità di fornire una diagnosi certa senza aumentare il carico radiante ottimizza il trattamento e migliora sensibilmente la prognosi del paziente con ictus acuto.
Per approfondire
Asmundo L., Zanardo M., Albano D., et al. Diagnostic accuracy of dual-energy CT in distinguishing intracerebral hemorrhage from contrast staining: a systematic review and meta-analysis with radiation dose assessment. La Radiologia Medica (2026).
https://doi.org/10.1007/s11547-026-02180-6
IA e screening opportunistico: predire il rischio di fratture vertebrali
Radiomica e TC per la gestione del tumore al seno in terapia ormonale
Le donne sottoposte a terapie di deprivazione estrogenica (HDT) per il tumore al seno presentano un rischio significativamente elevato di fragilità ossea. Tuttavia, la sola densitometria ossea (MOC-DEXA) spesso non è sufficiente a predire accuratamente il rischio di fratture. Un recente studio esplora come l’intelligenza artificiale applicata alle comuni scansioni TC (screening opportunistico) possa colmare questo gap diagnostico.
Il contesto: oltre la densità minerale ossea
Nelle pazienti in terapia ormonale, la microarchitettura ossea può deteriorarsi prima che si verifichi una riduzione significativa della densità minerale. La TC “opportunistica” , ovvero l’analisi di scansioni effettuate per altri motivi, come il follow-up oncologico, offre un’occasione unica per valutare la qualità dell’osso senza esami aggiuntivi.
Lo studio: radiomica e reti neurali
La ricerca ha utilizzato un approccio basato sull’IA per analizzare le vertebre lombari di 109 pazienti:
- Segmentazione automatica: una rete neurale convoluzionale (CNN) è stata impiegata per identificare e isolare automaticamente le vertebre nelle immagini TC.
- Analisi radiomica: sono state estratte centinaia di caratteristiche quantitative (RF) relative alla texture e alla forma dell’osso, invisibili all’occhio umano.
- Modello predittivo: è stato sviluppato un modello capace di distinguere tra pazienti che svilupperanno fratture vertebrali (VF) e quelle che rimarranno stabili.
I risultati: una nuova frontiera per la prevenzione
Il modello basato sulla radiomica ha mostrato prestazioni promettenti:
- Accuratezza: le caratteristiche di texture dell’osso si sono dimostrate predittori più affidabili rispetto ai parametri clinici tradizionali.
- Integrazione clinica: l’uso dell’IA permette di trasformare una TC di routine in uno strumento di screening preventivo per l’osteoporosi indotta da farmaci.
- Personalizzazione: identificare precocemente le pazienti ad alto rischio consente l’avvio tempestivo di terapie protettive (come i bisfosfonati), riducendo la morbilità a lungo termine.
Messaggio chiave
L’intelligenza artificiale applicata alla TC opportunistica rappresenta una svolta nella medicina di precisione per le pazienti oncologiche. Sfruttando dati già esistenti, il radiologo può fornire una valutazione del rischio di frattura accurata e personalizzata, migliorando significativamente la qualità di vita post-trattamento.
Per approfondire
Birtolo M. F., Levi R., Pagano M., et al. Artificial intelligence on opportunistic computed tomography for predicting vertebral fracture risk in women undergoing estrogen deprivation therapy for breast cancer. La Radiologia Medica (2026).
https://doi.org/10.1007/s11547-026-02172-6
Glossario radiologico
Caso clinico 1
Un uomo di 42 anni, in trattamento chemioterapico per leucemia mieloide acuta, presenta febbre persistente nonostante terapia antibiotica ad ampio spettro:
Qual è la diagnosi più probabile?
A. Polmonite batterica lobare
B. Aspergillosi polmonare invasiva
C. Embolia polmonare settica
D. Granulomatosi con poliangioite
E. Metastasi polmonare emorragica
Risposta corretta: B. Aspergillosi polmonare invasiva
L’halo sign alla TC torace è definito come area di attenuazione ground-glass che circonda un nodulo o una massa polmonare.
Meccanismo fisiopatologico
Nel contesto dell’aspergillosi invasiva, il segno riflette:
- angioinvasione fungina
- trombosi dei piccoli vasi polmonari
- necrosi ischemica centrale
- emorragia alveolare periferica
La zona centrale rappresenta il focolaio infettivo necrotico, mentre l’alone ground-glass corrisponde a emorragia alveolare peri-lesionale.
Contesto clinico tipico
Il segno ha maggiore valore diagnostico in pazienti:
- neutropenici
- sottoposti a chemioterapia
- trapiantati
- con immunosoppressione severa
Diagnosi differenziale
L’halo sign non è patognomonico e può comparire anche in:
- metastasi emorragiche (es. angiosarcoma, coriocarcinoma)
- vasculiti polmonari
- granulomatosi con poliangioite
- settic emboli
- infezioni virali
Nel contesto clinico corretto rimane tuttavia fortemente suggestivo di aspergillosi invasiva precoce.
Caso clinico 2
Un uomo di 67 anni arriva in PS con dolore addominale improvviso e vomito biliare.
A. Target sign
B. String sign
C. Whirlpool sign
D. Coffee bean sign
E. Thumbprinting sign
Risposta corretta: C. Whirlpool sign
Il Whirlpool sign è un segno radiologico tipicamente osservato alla TC addome con contrasto, caratterizzato da rotazione concentrica o spiraliforme dei vasi mesenterici e delle strutture adipose mesenteriche attorno a un asse vascolare centrale, generalmente rappresentato dall’arteria mesenterica superiore (SMA).
Meccanismo fisiopatologico
Questo pattern deriva da una torsione del peduncolo mesenterico, che comporta:
- rotazione delle anse intestinali
- avvolgimento dei rami venosi mesenterici
- compressione progressiva del ritorno venoso
La compromissione iniziale è venosa, con conseguente:
- congestione mesenterica
- edema della parete intestinale
- ispessimento parietale
- possibile progressione verso ischemia arteriosa e necrosi intestinale.
Contesti clinici principali
Il Whirlpool sign è classicamente associato a:
- Volvolo dell’intestino tenue
- Malrotazione intestinale complicata da midgut volvulus
- Volvolo post-chirurgico
- Internal hernia (ernie interne mesenteriche)
Nei pazienti adulti il reperto è più frequentemente associato a:
- volvolo del tenue
- ernie interne post chirurgiche (es. bypass gastrico).
Caratteristiche TC associate
Alla TC possono essere presenti ulteriori segni di sofferenza intestinale:
- dilatazione delle anse a monte
- edema e ispessimento parietale
- ridotta o assente enhancement parietale
- pneumatosi intestinale
- gas portale
- ascite reattiva
Caso clinico 3
Un uomo di 38 anni con HIV (CD4 < 100) presenta cefalea, febbre e deficit neurologico focale.
La RM encefalo mostra:
Qual è la diagnosi più probabile?
A. Metastasi cerebrali
B. Toxoplasmosi cerebrale
C. Ascesso batterico
D. Glioblastoma multiforme
E. Linfoma primitivo del SNC
Risposta corretta: B. Toxoplasmosi cerebrale
La toxoplasmosi cerebrale è la più comune infezione opportunistica del SNC nei pazienti con AIDS (CD4 <100 cellule/mm³).
Caratteristiche RM tipiche
Le lesioni presentano:
- enhancement ad anello
- edema vasogenico circostante
- localizzazione preferenziale nei gangli della base e nella giunzione cortico-sottocorticale
- possibile segno del target eccentrico.
Le sequenze più utili sono:
- T1 post-contrasto
- T2/FLAIR
- DWI
- perfusione
Differenziale principale
Il principale differenziale è il linfoma primitivo del SNC, che presenta:
- lesione più spesso solitaria
- localizzazione periventricolare
- restrizione alla diffusione più marcata
- elevata perfusione alla perfusion MRI
Caso clinico 4
Una donna di 32 anni, con storia di asma bronchiale persistente e frequenti riacutizzazioni, si presenta con tosse produttiva con escreato filamentoso e febbricola.
Quale segno radiologico è rappresentato?
A. Finger-in-glove sign
B. Halo sign
C. Air crescent sign
D. Crazy paving pattern
E. Reverse halo sign
Risposta corretta: A. Finger-in-glove sign
Il Finger-in-Glove Sign è un reperto radiologico caratteristico della bronchopneumopatia allergica da Aspergillus (ABPA), ma può essere osservato anche in:
- ostruzioni bronciali con muco inspissito
- bronchiectasie di altra origine
- raramente in tumori endobronchiali benigni o maligni.
Meccanismo fisiopatologico
- Le “dita di guanto” rappresentano bronchi dilatati e riempiti da materiale muco-proteico
- Il muco intrabronchiale può calcificare o diventare densamente radiopaco
- Si osserva spesso nei lobi superiori, più frequente nel contesto di asma cronico o ipersensibilità fungina
Imaging tipico
- TC HRCT: mostra bronchi dilatati, lineari o ramificati, riempiti di muco denso
- Aspetto “a dito di guanto”: materiale denso nel lume bronchiale che segue la morfologia bronchiale
- Può essere bilaterale o asimmetrico, spesso con bronchiectasie subcentrali
Contesto clinico
- Pazienti con asma cronica
- Elevati livelli di IgE totali e specifiche per Aspergillus
- Ricorrenti episodi di riacutizzazione bronchiale
- Essudato visibile nell’espettorato
Diagnosi differenziale
- Muco inspissito post-infezione batterica
- Bronchiectasie congenite o post-infettive
- Carcinoide endobronchiale con muco
- Polmonite ostruttiva (rare)
Ruolo clinico dell’imaging
- Confermare il sospetto di ABPA
- Valutare l’estensione delle bronchiectasie
- Monitorare la risposta alla terapia corticosteroidea o antifungina